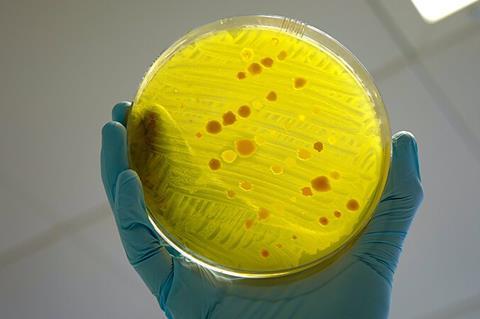
Antimicrobial_resistance

Baroness Natalie Bennett will join leading scientists and policymakers in Belfast for a discussion on how to slow the spread of superbugs at the Microbiology Society’s Annual Conference.
The former leader of the Green Party of England and Wales and member of the House of Lords will participate in a session on antimicrobial resistance (AMR) exploring how scientific research, policy and international collaboration can help address one of the most pressing global health challenges. Antimicrobial resistance occurs when microbes evolve to resist medicines, making infections harder to treat and increasing the risk of diseases spreading in humans and animals.
Baroness Bennett said: “Our awareness of new disease threats has grown in recent years, with Covid, avian influenza and many other threats now live. But insufficient attention continues to be paid to the dangers of long-term pathogens becoming immune to new and long-used drugs. Tuberculosis, typhoid and syphilis are just some of the most prominent dangers, with fungal diseases being seriously under-considered.
“I’m delighted to be speaking at the Microbiology Society conference to explain the work I’ve been doing to bring the superbug threat into mainstream politics and particularly to address particularly the risks of environmental drivers of resistance, including the unnecessary, profit-driven use of biocides in consumer products such as handwash, period products and mouthwash.”
Global challenges
The Microbiology Society’s Annual Conference is one of Europe’s largest microbiology events, bringing together researchers from around the world to present cutting-edge science and collaborate on solutions to global challenges including antimicrobial resistance.
Hosting the Conference highlights Belfast’s growing reputation as a destination for international scientific events, with hundreds of researchers expected to attend and engage with the city’s vibrant research and innovation community.
Speaking on the significance on the conference coming to Belfast, Judith Abraham, Head of Business Events at Visit Belfast, said: “We are delighted to welcome back the Microbiology Society’s Annual Conference to Belfast. Hosting an event with such global significance highlights the city’s growing reputation as a leading destination for large-scale international conferences. We are delighted to showcase Belfast’s world-class research community and deliver meaningful economic and societal impact for the city and wider region.”
This conference is supported by the Belfast & Northern Ireland conference subvention scheme from Belfast City Council & Tourism Northern Ireland, administered by Visit Belfast.







No comments yet